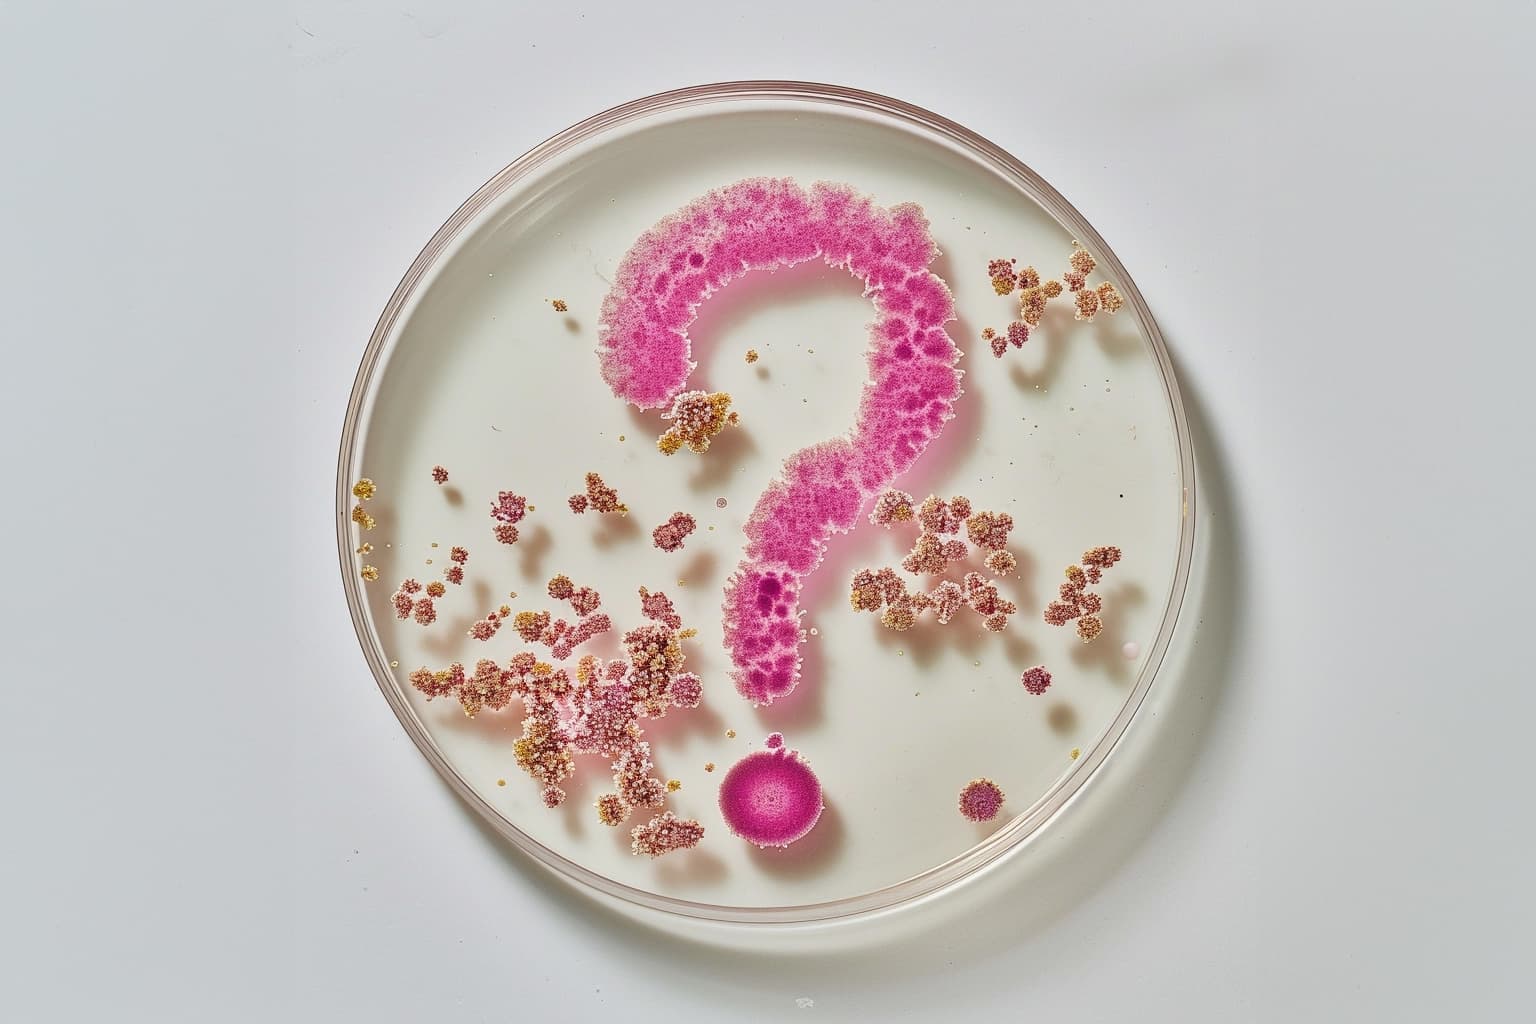

Was ist das endometriale Mikrobiom?
Verschiedene Organe unseres Körpers werden von Mikroorganismen besiedelt. Diese Mikroorganismen spielen eine entscheidende Rolle für Gesundheit, Wohlbefinden und natürliche physiologische Prozesse, indem sie beispielsweise die Verdauung unterstützen oder das Immunsystem beeinflussen und vor pathogenen Mikroben schützen. Das Mikrobiom des Darms oder der Haut unterscheiden sich aber deutlich vom Mikrobiom des weiblichen Reproduktionstrakts. Als endometriales Mikrobiom bezeichnet man entsprechend die Summe der Mikroorganismen, die auf der Gebärmutterschleimhaut (Endometrium) zu finden sind.
Wie hängen Mikrobiom und Kinderwunsch zusammen?
Das endometriale Mikrobiom wird mit unerfülltem Kinderwunsch in Verbindung gebracht. Probleme wie Implantationsversagen, wiederholte Fehlgeburten oder ungeklärte Infertilität können mit einer „Fehlbesiedelung“ und/oder einer Infektion der Gebärmutterschleimhaut zusammenhängen. Ein gesundes endometriales Mikrobiom wird von Laktobazillen dominiert, Bakterien, die physiologischerweise v.a. auch im unteren Genitaltrakt zu finden sind und mit einer höheren Wahrscheinlichkeit für eine erfolgreiche Schwangerschaft in Verbindung gebracht wird.

Wann ist eine Untersuchung des endometrialen Mikrobioms sinnvoll?
Die Untersuchung des endometrialen Mikrobioms mit unserem ebiom-Test ist sinnvoll für Frauen, die Schwierigkeiten haben, schwanger zu werden oder wiederholte Fehlgeburten erleiden. Die Analyse kann Aufschluss darüber geben, ob ein Ungleichgewicht in der mikrobiellen Besiedlung der Gebärmutter vorliegt, das die Einnistung des Embryos oder den Erhalt der Schwangerschaft möglicherweise beeinträchtigt.

Was ist chronische Endometritis (CE)?
Chronische Endometritis (CE) ist definiert als eine anhaltende Entzündung der Gebärmutterschleimhaut, die häufig mit wiederholtem Implantationsversagen und wiederholtem Schwangerschaftsverlust einhergeht. Obwohl die chronische Endometritis in der Regel ohne Symptome verläuft, können chronische Unterleibsschmerzen, Dyspareunie (Schmerzen beim Geschlechtsverkehr), abnormale vaginale Blutungen oder Ausfluss auftreten. Auslöser einer CE können sexuell übertragbare Erreger sein, auch wenn der ursprüngliche Infektionszeitpunkt einige Zeit zurückliegt. Liegen Symptome vor, die für eine CE sprechen empfiehlt sich die zielgerichtete und sensitive Suche nach pathogenen Erregern (Chlamydia trachomatis, Neisseria gonorrhoeae, Ureaplasma urealyticum/parvum, Mycoplasma hominis/genitalium) mit unserem ebiomCE Test.

Was verbirgt sich hinter ebiom+?
ebiom+ kombiniert ebiom und ebiomCE für ein umfassendes mikrobiologisches Bild des Endometriums. Es beschreibt physiologische Zustände (Lactobacillen), Dysbiose (potentiell pathogene Besiedlung) und bekannte Krankheitserreger (ebiomCE), um optimale Empfehlungen aussprechen zu können.

Test-Optionen
TEST
|
ÜBERSICHT
|
TECHNOLOGIE
|
ebiom+ | Kombination aus ebiom und ebiomCE für eine umfassende mikrobielle Beschreibung des Endometriums | Next-Generation-Sequencing (NGS) & Real-Time Multiplex Polymerase Chain Reaction (PCR) |
ebiomCE | Identifiziert häufige sexuell-übertragbare Erreger zielgerichtet und mit hoher Sensitivität | Real-Time Multiplex Polymerase Chain Reaction (PCR) |
ebiom | Beschreibt die universelle bakterielle Besiedlung des Endometriums, inklusive Lactobacillen (physiologisch) und dysbiotische Zustände. | Next-Generation-Sequencing (NGS) |
Welche Informationen enthält der Befund?
Nach der Analyse Ihres Mikrobioms erhalten Sie einen ausführlichen Befund, der folgende Informationen enthält:
- Tabellarische Übersicht der nachgewiesenen Bakterien und deren relative Häufigkeit
- Shannon-Index (Maß für Unterschiedlichkeit und Häufigkeit der nachgewiesenen Bakterien)
- Interpretation des Ergebnisses
- ggfs. Hinweise zu therapeutischen Maßnahmen
- Allgemeine Informationen zur Untersuchung
- Angewandte Untersuchungstechnik
- Bei ebiom+ tabellarische Übersicht des ebiomCE Tests

Was tun bei einem auffälligen ebiom+ Befund?
Eine Behandlung pathogener Bakterien mit Probiotika und/oder Antibiotika ist in Abstimmung mit der behandelnden Ärztin möglich. Unser ebiom-Befund enthält Hinweise zu möglichen therapeutischen Maßnahmen.

FAQs zum ebiom+ Test
Sie haben Fragen?
Für eine ausführliche Beratung und Fragen zum Test und zu den Ergebnissen können Sie uns telefonisch, per E-Mail oder über unser Kontaktformular erreichen.
Tel.: +49.89.895578-0
Fax: +49.89.895578-780
E-Mail: info@medicover-diagnostics.de
Wir sind werktags (Montag – Freitag) von 08.00 – 18.00 Uhr für Sie erreichbar.